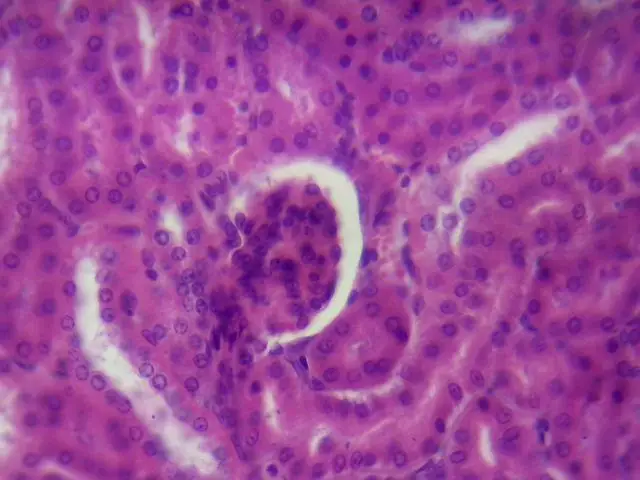

100 pièces/ensemble lames de Microscope échantillon de verre biologique préparé base animaux plantes insectes tissus Science spécimen couverture glisse
30.99
$
10
commandes
/
1
avis
Évolution du prix
- pour 3 mois
- pour un semestre
- Nécessite l'extension Alitools
L'extension Alitools est nécessaire pour suivre un article et recevoir des notifications lorsque les prix baissent.
Avis de baisse de prix
29.44 $ (-5%)
29.44 $ (-5%)
27.89 $ (-10%)
26.34 $ (-15%)
24.79 $ (-20%)
Notre bot Telegram vous informera dès que le prix aura baissé jusqu'au prix souhaité
Cet article provient d'autres vendeurs
Produits similaires
Avis clients
M***t
13 janvier 2021
conforme, pas de casse. parfait
A***l
8 janvier 2021
98 samples was ok, 2 was broken.
Anonyme